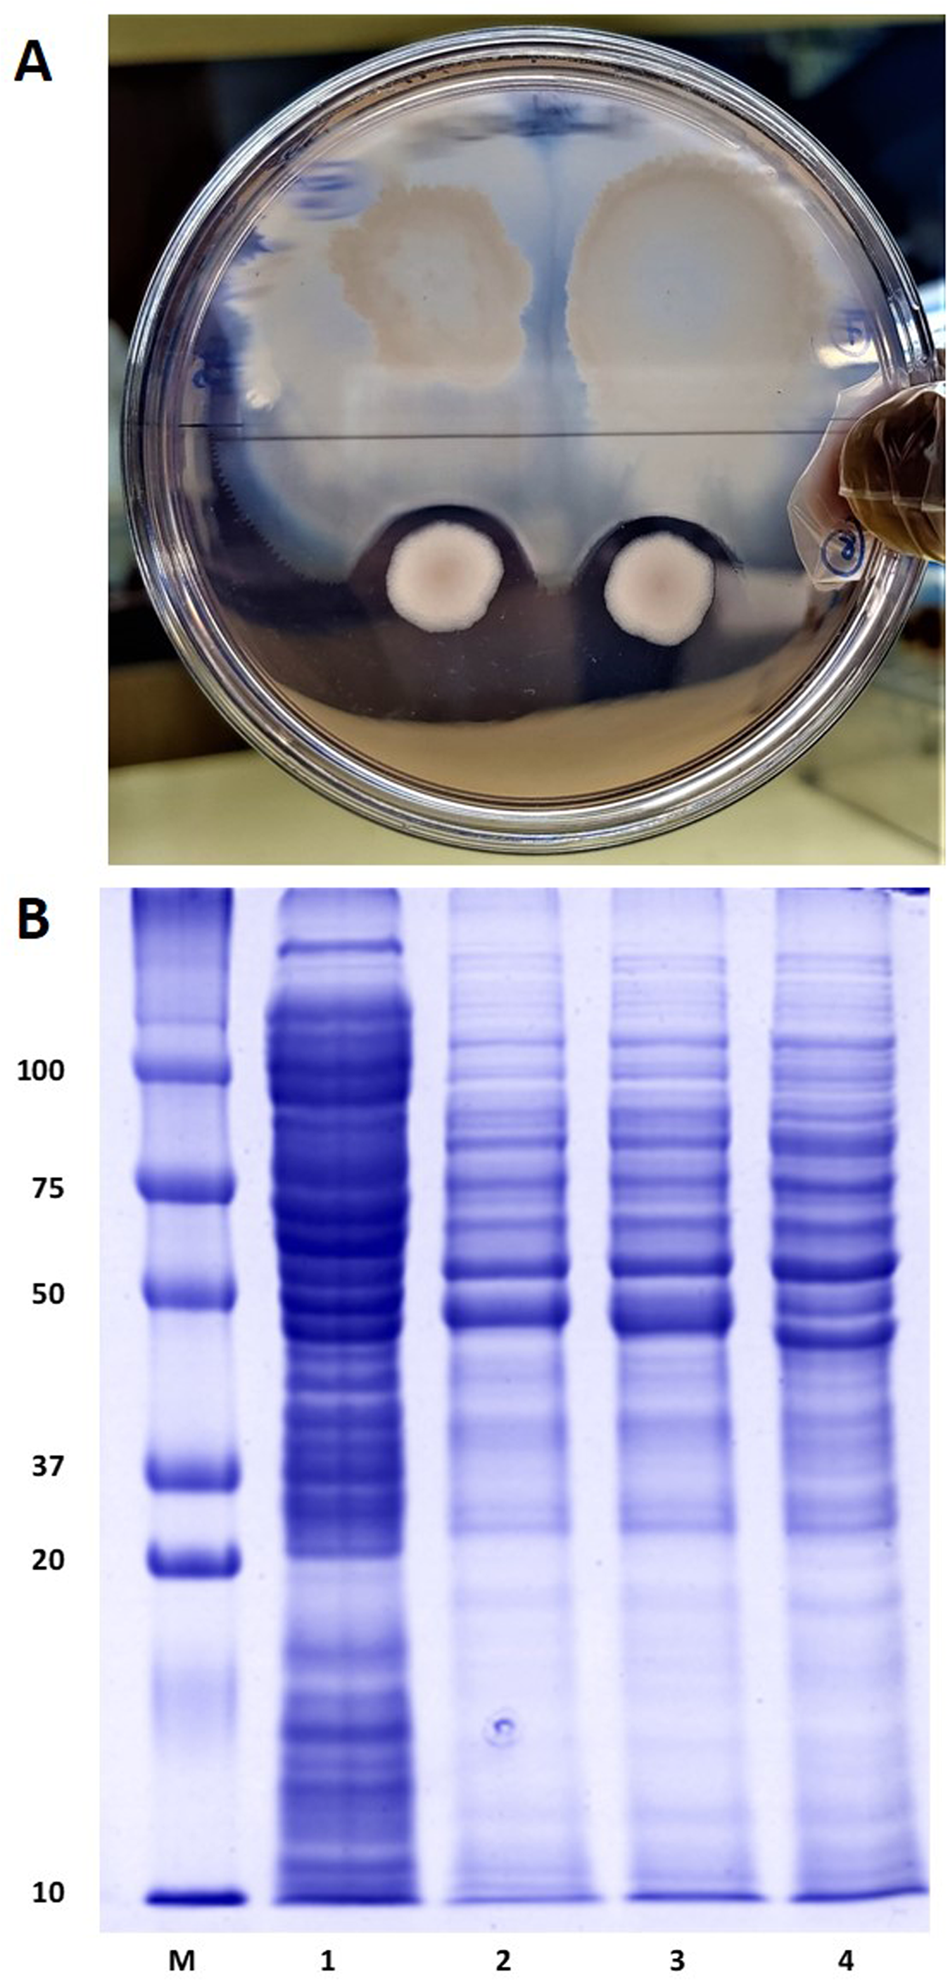
Fig. 6

Fig. 6: Characterisation of antibacterial assay of non-pathogenic bacterial isolates.
A Antibacterial assay of non-pathogenic bacteria isolates and extracellular proteins (ECPs) against pathogenic bacteria. The non-pathogenic bacteria suspension/ ECP were cultured on TSA plates. After 24–48 h incubation at 37 °C, the diameters of inhibition halos surrounding the non-pathogenic bacteria suspension/ ECP were measured and expressed in millimetres. B SDS-PAGE analysis of extracellular proteins (ECPs) concentrated from bacterial cell free supernatant filtered with a 3 kDa cut-off size amicon filter. Molecular mass standards (M) in kilodaltons (Protein ladder) are shown on the left. Lane 1 - Citrobacter freundii A9 ECP3, Lane 2 - Bacillus subtilis C4 ECP3, Lane 3 - B. subtilis OC2 ECP3 and Lane 4 - B. safensis OC1 ECP3.